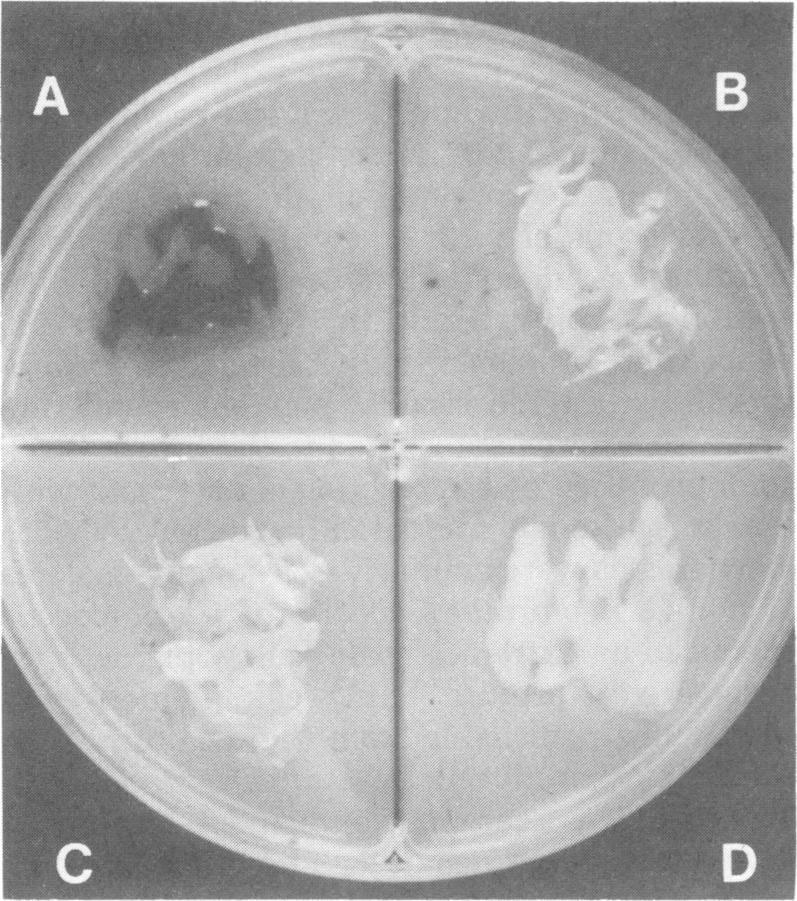
https://cdn.ncbi.nlm.nih.gov/pmc/blobs/5d7e/273586/b70145a54909/jcm00170-0060-a.jpg

用于新型隐球菌分离和鉴定的七叶苷培养基
Esculin-based medium for isolation and identification of Cryptococcus neoformans.
作者信息
Edberg S C, Chaskes S J, Alture-Werber E, Singer J M
出版信息
J Clin Microbiol. 1980 Sep;12(3):332-5. doi: 10.1128/jcm.12.3.332-335.1980.
A simple medium was developed, using esculin as the substrate, for the isolation and identification of Cryptococcus neoformans. C. neoformans produced a brown-black pigment on the medium; all other yeasts produced no pigment or were light yellow. Esculin is beta-glucose-6,7-dihydroxycoumarin. C. neoformans produced pigment because the 6,7-dihydroxycoumarin component of the esculin molecule was converted to a melanin-like pigment. We think the reaction was similar to the conversion of diphenols, aminophenols, and diaminobenzenes to melanin. Laboratory studies with isolates of C. neoformans, C. albidus, C. luteolus, and C. terreus and representatives of the genera Candida, Torulopsis, Geotrichum, and Rhodotorula, plus environmental field studies, demonstrated that over 95% of C. neoformans isolates were correctly identified, whereas all other fungi were excluded. Esculin agar was a sensitive, specific medium for the isolation and identification of C. neoformans. It was inexpensive and had a long storage life.
开发了一种以七叶苷为底物的简单培养基,用于新型隐球菌的分离和鉴定。新型隐球菌在该培养基上产生棕黑色色素;所有其他酵母均不产生色素或呈浅黄色。七叶苷是β-D-葡萄糖-6,7-二羟基香豆素。新型隐球菌产生色素是因为七叶苷分子的6,7-二羟基香豆素成分转化为类黑色素。我们认为该反应类似于二酚、氨基酚和二氨基苯转化为黑色素的过程。对新型隐球菌、浅白隐球菌、淡黄隐球菌、土生隐球菌的分离株以及念珠菌属、球拟酵母属、地霉属和红酵母属的代表菌株进行的实验室研究,以及环境现场研究表明,超过95%的新型隐球菌分离株能够被正确鉴定,而所有其他真菌均被排除。七叶苷琼脂是用于新型隐球菌分离和鉴定的一种敏感、特异的培养基。它价格低廉且储存寿命长。